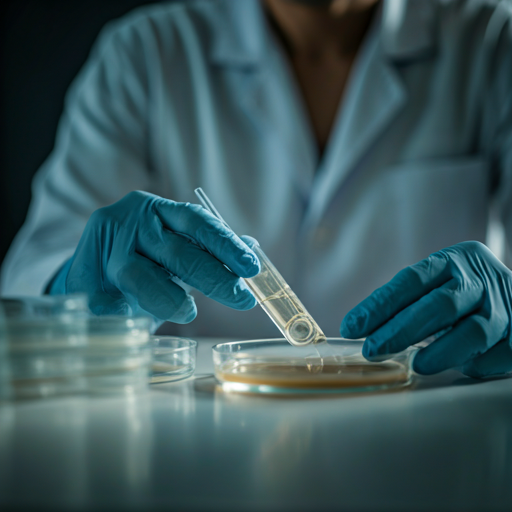

Professional inspection and testing services tailored for safety and compliance. We provide the data you need to ensure a healthy indoor environment.
Reliable assessments using industry-standard methodology and certified laboratory analysis.

Comprehensive on-site assessment for visible mold growth and underlying moisture issues through visual and moisture mapping techniques.
Detailed air and surface sampling options to identify mold species and concentrations. Results are verified by AIHA-LAP certified labs.

Indoor air screening for common concerns including VOCs, allergens, and particulates. Essential for commercial and residential health audits.

Bulk sampling of suspect materials including flooring, insulation, and siding. Crucial before any renovation or demolition project.
Our team is on standby 24/7. Whether it's a burst pipe, smoke damage, or air quality concerns, we provide professional, disciplined response.